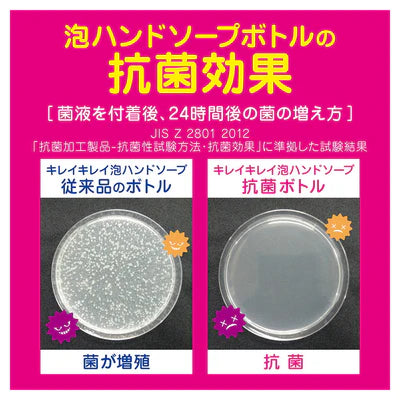
Japan LION Lion King Sterilizing Children's Hand Sanitizer-Pink

- SKU:
- BARCODE: 4903301240990
- VENDOR: 狮王Lion
Japan LION Lion King Sterilizing Children's Hand Sanitizer-Pink
Shipping calculated at checkout.
Couldn't load pickup availability
Guaranteed Safe Checkout
Description
Medicinal disinfection + disinfection protection of hand skin disinfection care properly disinfects and protects your hand skin from bacteria, the best-selling product. 1. Beautiful medicinal foam hand soap ●Adopts antibacterial pump head, does not increase bacteria ●Proper disinfection, protects hands from bacteria ●Delicate foam, captures dirt in every corner and removes it thoroughly ●Quickly removes foam, washes without stickiness
Shipping & Returns
- Free shipping on orders over $100 within Ontario
- Standard delivery within 3–7 business days
Standard delivery within 3–7 business days